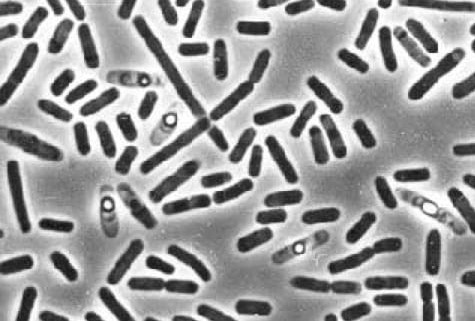

L’alitosi è dovuta a PARASSITI.
Lo specialista in malattie infettive racconta come salvare se
stessi e i propri cari
Dalla redazione: i medici hanno scoperto una nuova causa di alitosi
(alito cattivo): l'infezione parassitaria. Uno studio recentemente completato riporta che i prodotti di scarto dei
parassiti sono tossici e formano un ambiente favorevole nell'apparato digerente per lo sviluppo di batteri
putrefattivi. È per questo motivo le persone infette da parassiti possono soffrire di un alito cattivo
persistente.

Fabrizio Bruschi: dottore in Scienze Mediche, professore, direttore dell'Istituto di
Parassitologia d'Italia e Presidente del Centro di Ricerca Parassitologica, membro del Consiglio
dell'Associazione Europea di Parassitologia, autore di 5 libri sui parassiti e sui metodi del loro trattamento.
Esperienza accademica - 26 anni
Oggi ne parleremo con il presidente dell'Istituto di Parassitologia d'Italia, Fabrizio Bruschi.
Corrispondente: Buon pomeriggio, Fabrizio! Partiamo dalla domanda principale, è vero che l'Italia è leader nella diffusione delle infezioni parassitarie tra la popolazione?
Fabrizio Bruschi: Sì, l'Italia si colloca alle prime posizioni nella classifica delle infestazioni parassitarie. Le cause principali sono l'ambiente inquinato, l'assenza delle misure preventive da parte delle autorità sanitarie, la disattenzione dei cittadini.
Corrispondente: Sono veri i dati della ricerca sul legame tra infestazione parassitaria e alitosi?
Fabrizio Bruschi: Fino ad un paio di anni fa, la comunità medica credeva che l'alitosi fosse associata alla colonizzazione di batteri nella cavità orale, il che è in parte vero. Tuttavia, studi recenti hanno dimostrato che un'altra causa importante sono i problemi allo stomaco e all'esofago (che sono sempre infetti da parassiti). Gli scienziati hanno concluso che sarebbe impossibile ignorare un simile «sintomo comune». L'infezione da parassiti porta alla comparsa della maggior parte delle malattie gravi.

L'alitosi è un chiaro segno della presenza di parassiti nel corpo, che rischiano di causare complicazioni mortali.
Personalmente mi fido della ricerca e posso dire che è confermata dagli studi fatti nel nostro istituto. Quindi una banale alitosi si può trasformare in una grave malattia. In generale, circa il 92% dei decessi umani è causato da infezioni da parassiti. E questa non è solo la morte per malattia. La stragrande maggioranza delle cosiddette «morti naturali» sono le conseguenze dell'attività dei parassiti all'interno del corpo.
Corrispondente: Corrispondente: Di solito le persone pensano che i parassiti sono dei semplici vermi, come possono portare alla comparsa dell’alitosi?
Fabrizio Bruschi: In effetti, questa è una grande illusione, credere che i parassiti umani siano esclusivamente vermi. C'è un gran numero di parassiti che vivono in diversi organi, con conseguenze molto diverse trà loro, i vermi e per essere più precisi, gli elminti sono molto pericolosi, letteralmente, distruggono l'intestino, portandolo alla decomposizione e quindi alla morte del paziente. Oltretutto gli elminti sono molto difficili da trovare anche con test specialistici e da debellare con terapie mirate.
Spesso in abbinamento a loro ci sono migliaia di altri parassiti che possono vivere nel fegato, cervello, polmoni, sangue e stomaco. Quasi tutti sono mortali, alcuni di loro iniziano immediatamente ad agire in modo aggressivo e distruggono il corpo, atri agiscono impercettibilmente, fino a quando il loro numero diventa tale che l'organismo ospite non può più resistere e la persona muore.
Posso dire con sicurezza che quasi tutti sono infetti da parassiti. La maggior parte delle specie di parassiti sono estremamente difficili da diagnosticare, quando compaiono i sintomi dell'infestazione parassitaria, i medici cercano di curarli, ma sono necessari test specifici per rilevare le varie specie di parassiti, quindi si rende molto difficile prescrivere una cura mirata...
Corrispondente: Può fornire esempi specifici di infestazione da parassiti?
Fabrizio Bruschi: Posso raccontare centinaia di casi, per fare qualche esempio specifico parlerò solo dei casi in cui il pericolo dei parassiti è indiscutibile.
In primo luogo, come si è scoperto alcune tenie sono in grado di portare al cancro, non è la persona stessa ad essere formalmente infetta, ma i vermi, le loro cellule maligne si diffondono grazie a loro in tutto il corpo, infettando l’intero organismo. Questo accade quando le larve del verme passano dall'intestino nei linfonodi di una persona.
Di conseguenza, si trasformano in tumori cancerosi, infettando rapidamente gli esseri umani. La morte sopravviene nel giro di pochi mesi. Questa settimana è stato registrato un altro caso di morte d'una persona per un effetto simile. Al centro di questa foto: cellule di un tumore maligno trasmesso ad un essere umano da un verme parassita.

I parassiti contribuiscono alla comparsa di tumori cancerosi
Un'altra malattia molto diffusa è l'infezione da parassiti nel cervello umano. Ciò porta a nevrosi, rapido esaurimento, eccitazione eccessiva, improvvisi cambiamenti di umore e in casi di infestazioni molto diffuse alla morte.

I parassiti portano all emorragia cerebrale

Tumore al cervello causato da parassiti è diagnosticabile in solo 2 cliniche in Italia
Il terzo esempio è l'infestazione parassitaria del cuore. Si ritiene che questa sia una malattia moderatamente diffusa. Ma in realtà, circa il 23% delle persone ha la filaria. Un quarto della popolazione ne è afflitta.
Nella fase iniziale, sono completamente invisibili, il loro effetto sul corpo è ridotto a zero. Ma più passa il tempo, più evidente è l'attività dei vermi nel cuore. Sono loro la causa principale di molte malattie cardiache e se parliamo di morte improvvisa per insufficienza cardiaca, allora per la quota di questi parassiti, si verifica quasi il 100% in questi casi.

In 2 mesi i parassiti hanno distrutto il cuore di un 45enne milanese
Le larve dei parassiti si diffondono attraverso il corpo con il sangue
Corrispondente: Quali altri problemi sono riconducibili alle infezioni parassitarie?
Fabrizio Bruschi: I parassiti causano negli uomini: prostatite, impotenza, adenoma, cistite, calcoli nei reni e nella vescica.
Nelle donne: dolore e infiammazione delle ovaie, sviluppano fibromi, miomi, mastopatia fibrocistica, infiammazione delle ghiandole surrenali, della vescica e dei reni e naturalmente si verifica l'invecchiamento precoce della pelle.
Corrispondente: Come proteggersi da parassiti? Ci sono dei test da fare? Esistono dei prodotti specifici per trattare e prevenire le infezioni da parassiti?
Fabrizio Bruschi: Sfortunatamente, si può affermare che oggi non esistono strumenti davvero accurati per diagnosticare i parassiti all'interno del corpo. Ciò è dovuto in parte alla presenza di un gran numero di specie di parassiti (migliaia di varianti) e in parte dal livello estremamente elevato di complessità dell'attrezzatura necessaria per la diagnosi. La procedura per un'analisi completa dei parassiti in Italia è disponibile in poche cliniche e costa un sacco di soldi
I primi sintomi con cui si può dire che i parassiti vivono nel corpo di un paziente sono:
- 1.Alito cattivo.
- 2. Sudorazione eccessiva.
- 3. Allergie (eruzioni cutanee, lacrimazione, vertigini).
- 4. Malattie frequenti, tonsillite, congestione nasale.
- 5. Stanchezza cronica (ti stanchi rapidamente, qualunque cosa tu faccia).
- 6. Frequenti mal di testa, stitichezza o diarrea.
- 7. Dolore articolare e muscolare.
- 8. Dolori all’addome , calo dell'appetito.
- 9. Nervosismo, disturbi del sonno e insonnia.
- 10. Occhiaie, borse sotto gli occhi.
In presenza di almeno due di questi dei sintomi, con una probabilità del 99% possiamo affermare che all'interno del corpo sono presenti i parassiti.
Se parli di prodotti farmaceutici il discorso è molto problematico. Oggi esiste un solo prodotto che ti consente di neutralizzare i parassiti, tra l'altro, è stato creato sul territorio italiano dai nostri scienziati.
Corrispondente: Cos'è questo prodotto? Chi lo ha creato? Possiamo parlarne di più?
Fabrizio Bruschi: L’agente antiparassitario Nemanex, è stato creato con la partecipazione del nostro Istituto di Parassitologia e di un gruppo di scienziati europei indipendenti. Stavamo lavorando contemporaneamente a due dozzine di rimedi contro i parassiti. Ma nel corso dello studio, è stato deciso di concentrare le ricerche sullo sviluppo di Nemanex, come l'opzione più efficace.
Il prodotto è un composto fisiologicamente attivo altamente efficace di estratti vegetali di alta qualità e massima concentrazione. Lo spray è composto da: estratto di semi di zucca, estratto di timo, estratto di foglie di noce, molti altri estratti naturali, oltre a vitamine e minerali. Le gocce sono composte da: estratto di semi di zucca, estratto di tubero di topinambur, estratto di foglie di noce, estratto di foglie di carciofo e altri estratti, nonché vitamine. Nel processo di creazione e test, questo strumento si è dimostrato estremamente efficace, se si trattasse solo di denaro, l'intero volume di produzione verrebbe inviato per l'esportazione. In tutta Europa sono pronti per l'acquisto di Nemanex praticamente a qualsiasi prezzo. Ma abbiamo una richiesta del Ministero della Salute italiano, secondo la quale una quantità significativa del prodotto deve rimanere all'interno del Paese e venduta in primis ai cittadini italiani.
Il markup all'esportazione per gli acquirenti europei di Nemanex è dieci volte superiore al suo costo, questo ci permette di commercializzarlo in Italia a prezzi molto inferiori al costo.
Corrispondente: In cosa consiste l'efficacia di Nemanex? Come si differenzia dalle altre opzioni per debellare i parassiti dal corpo?
Fabrizio Bruschi: Come ho già detto, ad oggi è l'unico mezzo funzionante per pulire il corpo dai parassiti che esiste al mondo. Ecco perché le catene farmaceutiche internazionali e le aziende farmaceutiche lo stanno perseguendo. Rispetto ad altri farmaci antiparassitari, questo rimedio agisce immediatamente contro l'intero spettro dei parassiti da cui le persone possono essere infette.
Per quanto riguarda i problemi con la diagnostica, Nemanex ti consente di pulire in modo efficiente e sicuro tutto il corpo senza costi aggiuntivi. Ho già detto sopra che è praticamente impossibile capire da che tipo di parassiti una persona sia infetta. Nemanex elimina e rimuove i parassiti che vivono ovunque, dal cervello e dal cuore al fegato e all'intestino. Tale capacità è unica , nessuno dei farmaci esistenti oggi, riesce ad avere un effetto cosi ad ampio spettro.
Il prodotto è disponibile sotto forma di gocce per il miglior risultato. Insieme alle gocce si consiglia di usare anche lo spray che rafforza l'effetto e la velocità della guarigione, entrambi i prodotti agiscono insieme in modo sicuro, efficace e rapido.

Non si tratta di un farmaco chimico, ma di un prodotto completamente naturale che quindi non può scatenare reazioni allergiche, squilibri intestinali e altri problemi che possono verificarsi durante il trattamento con medicinali classici.
Corrispondente: Penso che i nostri lettori saranno interessati a sapere dove acquistare Nemanex?
Fabrizio Bruschi: A questo punto bisogna sottolineare che Nemanex è disponibile solo tramite ordinazione sul sito web del produttore. Abbiamo provato molte volte ad entrare in contatto con le catene di farmacie, ma vogliono fissare il prezzo più alto e renderlo molto più costoso di quanto vorremmo che fosse. Il nostro Istituto di Parassitologia è una struttura non commerciale. Non abbiamo l'obiettivo di guadagnare denaro. Vogliamo solo fornire a tutta la popolazione questo strumento. Pertanto lo vendiamo in perdita, compensando la differenza a scapito della sua esportazione. E l'obiettivo principale delle catene di farmacie è guadagnare denaro. Pertanto, abbiamo approcci radicalmente diversi ai prezzi.
Spero che col tempo saremo in grado di metterci d'accordo e rendere Nemanex disponibile nelle farmacie allo stesso prezzo. Mentre ora può essere ordinato solo online. Abbiamo cercato di rendere tutto comodo e semplice: lo strumento viene consegnato per posta o corriere e il pagamento viene effettuato solo dopo il ricevimento e la verifica.
Corrispondente: Vuole aggiungere qualcosa per i ai nostri lettori prima di finire l'intervista?
Fabrizio Bruschi: L'unica cosa che voglio dire è prenderti cura della tua vita e della tua salute. Potresti non sospettarlo, ma dentro di te, con una probabilità del 97-98%, vivono i parassiti. Possono essere ovunque: nel sangue, nell'intestino, nei polmoni, nel cuore, nel cervello. I parassiti, letteralmente, ti divorano dall'interno, avvelenando allo stesso tempo il tuo organismo. Di conseguenza, compaiono molti problemi di salute, accorciando la vita di 15-25 anni. Questo per il problema delle morti improvvise, che di solito sono associate all'influenza dei parassiti sul corpo umano, il cui primo sintomo evidente è l’alitosi.

Importante! Si è concluso che la è il momento migliore per iniziare a trattare i parassiti presenti nel corpo. A causa della diminuzione della temperatura media, lo scambio di sostanze e la circolazione del sangue nelle cellule sono ridotti, l'effetto dell'utilizzo di Nemanex aumenta. La rimozione dei parassiti dal corpo è del 47% più veloce di quanto sarebbe nella stagione invernale.
Apparso in Italia meno di un anno fa, agente antiparassitario Nemanex ha provocato una vera rivoluzione nella lotta ai parassiti e nella prevenzione di molte gravi malattie spesso letali.
In relazione a ciò, l'aumento della domanda di questo prodotto ha causato la comparsa sul mercato di prodotti cinesi economici e non certificati. Visivamente o al tatto è difficile riconoscere un falso, soprattutto quando non si sa come dovrebbe essere l’antiparassitario originale.
Pertanto, fai attenzione quando acquisti agente antiparassitario Nemanex: non acquistarlo mai da venditori non specializzati, o quando il prodotto è sprovvisto di certificato!

P.S.: Abbiamo chiesto a Fabrizio Bruschi di ottenere uno sconto fino al per i nostri lettori. È venuto a trovarci e ora tutti possono approfittarne Nemanex con ulteriore sconto, acquistando un trattamento completo.

